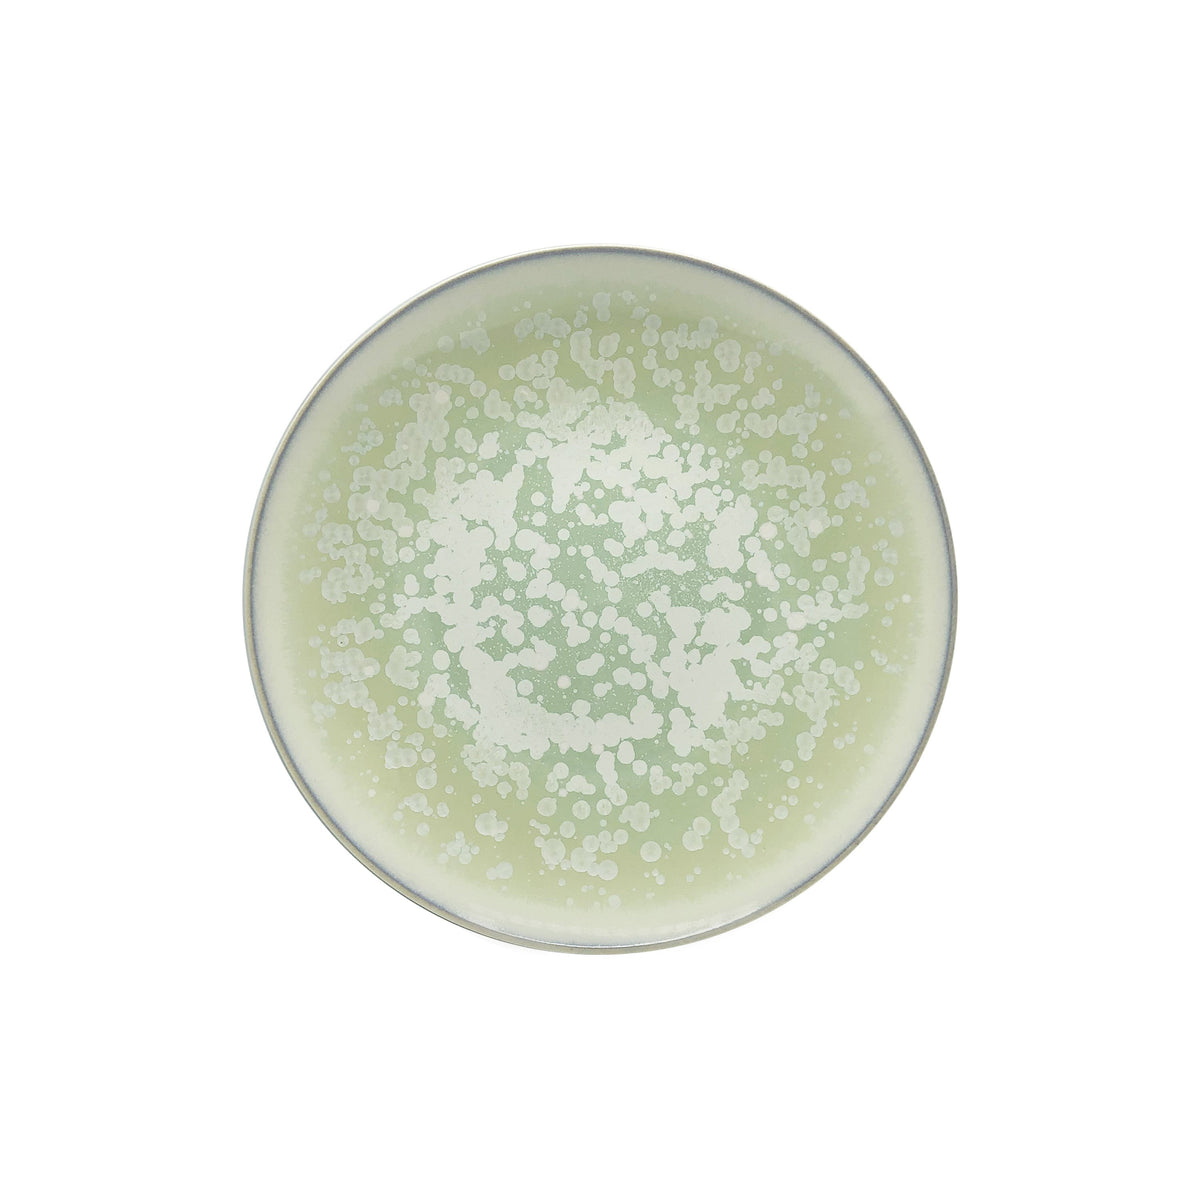
JL Coquet  SONG Amande - Assiette ? dessert, Agora 8.27 Inch SKU: AGO1028SGAMCREM000

Only the best and most reputable European tableware and hospitality brands
Contact Us
Phone: 802-222-6994
Email: CS@hospitalityprovisions.com
2300 E. Lincoln Hwy
Showroom 218
Langhorne, PA 19047
Connect
Join our mailing list for updates
Join us and get nice things
Free stuff and general goodness
*By completing this form you're signing up to receive our emails and can unsubscribe at any time.
Draft order has been created successfully.
Add address